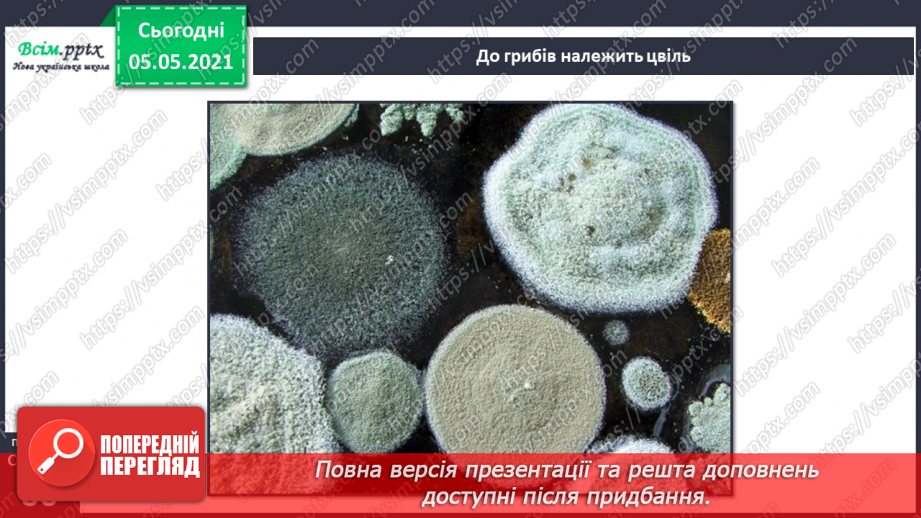

- Підготовка до школи
- Ранкові кола. Виховні години
-
Початкова школа. 1 клас
-
Навчання грамоти
- Навчання грамоти. Посібник. Пономарьова К. І. 1 клас. 2023 року випуску
- Навчання грамоти. Посібник. Вашуленко М. С., Вашуленко О. В., Прищепа О.Ю. 1 клас. 2023 року випуску
- Навчання грамоти. Посібник. Н.М. Кравцова, О.Д. Придаток. 1 клас. 2023 року випуску
- Навчання грамоти. Вашуленко М. С., Вашуленко О. В. 1 клас [2018-2022]
- Навчання грамоти. Пономарьова К. І. 1 клас [2018-2022]
- Українська мова. Большакова І. О., Пристінська М. С. 1 клас. [2018-2022]
- Навчання грамоти. Захарійчук М. Д. 1 клас. [2018-2022]
- Навчання грамоти. Н.М. Кравцова, О.Д. Придаток. 1 клас. [2018-2022]
-
Математика
- Математика. Посібник. Листопад Н. П. 1 клас. 2023 року випуску
- Математика. Посібник. Скворцова С. О., Онопрієнко О. В. 1 клас. 2023 року випуску
- Математика. Посібник. Заїка А. Тарнавська С. 1 клас. 2023 року випуску
- Математика. Посібник. О.Гісь та І. Філяк. 1 клас. 2023 року випуску
- Математика. Скворцова С. О., Онопрієнко О. В. (зош. 4 частини) 1 клас [2018-2022]
- Математика. Листопад Н. П. 1 клас. [2018-2022]
- Математика. Лишенко, Г. П., Тарнавська, С. С., Лишенко, К. О. 1 клас. [2018-2022]
- Математика. Гісь О. М., Філяк І. В. 1 клас. [2018-2022]
- Математика. Заїка А. М. 1 клас. [2018-2022]
- Математика. С. П. Логачевська Т. А. Логачевська О. А. Комар. 1 клас. [2018-2022]
-
Я досліджую світ
- Я досліджую світ. Гільберг Т. Г., Тарнавська С. С., О. В., Павич Н. М. 1 клас. 2023 року випуску
- Я досліджую світ. Н. Бібік, Г. Бондарчук. 1 клас. 2023 року випуску
- Я досліджую світ. Волощенко О. В., Козак О. П., Остапенко Г. С. 1 клас. 2023 року випуску
- Я досліджую світ. Т. В. Воронцова, В. С. Пономаренко, О. Л. Хомич. 1 клас. 2023 року випуску
- Я досліджую світ. І. Жаркова, Л. Мечник, Л. Роговська. 1 клас. 2023 року випуску
- Я досліджую світ. Гільберг Т. Г., Тарнавська С. С., Гнатюк О. В., Павич Н. М. 1 клас [2018-2022]
- Я досліджую світ. Бібік Н. М., Бондарчук Г. П. 1 клас [2018-2022]
- Я досліджую світ. Грущинська І. В., Хитра З. М., Дробязко І. І. 1 клас. [2018-2022]
- Я досліджую світ. Большакова І.О., Пристінська М.С. 1 клас. [2018-2022]
- Я досліджую світ. Волощенко О. В., Козак О. П., Остапенко Г. С. 1 клас. [2018-2022]
- Я досліджую світ. Т. В. Воронцова, В. С. Пономаренко, О. Л. Хомич, І. В. Гарбузюк, Н. В. Андрук, К. С. Василенко. 1 клас. [2018-2022]
-
Дизайн і технології
- Дизайн та технології. Гільберг Т. Г., Тарнавська С. С., Гнатюк О. В., Павич Н. М. 1 клас. 2023 року випуску
- Дизайн і технології. Бібік Н. М., Бондарчук Г. П. 1 клас. 2023 року випуску
- Дизайн і технології. Волощенко О. В., Козак О. П., Остапенко. 1 клас. 2023 року випуску
- Дизайн і технології. Т. В. Воронцова, В. С. Пономаренко. 1 клас. До підручника 2023 року випуску
- Дизайн та технології. Гільберг Т. Г., Тарнавська С. С., Гнатюк О. В., Павич Н. М. 1 клас. [2018-2022]
- Дизайн і технології. Бібік Н. М., Бондарчук Г. П. 1 клас. [2018-2022]
- Дизайн і технології. Грущинська І. В., Хитра З. М., Дробязко І. І. 1 клас. [2018-2022]
- Дизайн і технології. Волощенко О. В., Козак О. П., Остапенко Г. С. 1 клас. [2018-2022]
- Дизайн та технології. Т. В. Воронцова, В. С. Пономаренко, О. Л. Хомич, І. В. Гарбузюк, Н. В. Андрук, К. С. Василенко. 1 клас. [2018-2022]
-
Мистецтво
- Образотворче мистецтво. Л. Масол, О. Гайдамака, О. Колотило. 1 клас. 2023 року випуску
- Музичне мистецтво. Л. Масол, О. Гайдамака, О. Колотило. 1 клас. 2023 року випуску
- Образотворче мистецтво. Калініченко О. В. 1 клас. 2023 року випуску
- Музичне мистецтво. Калініченко О. В. 1 клас. 2023 року випуску
- Образотворче мистецтво. Л. Аристова, Н. Чєн. 1 клас. 2023 року випуску
- Музичне мистецтво. Л. Аристова, Н. Чєн. 1 клас. 2023 року випуску
- Образотворче мистецтво. Масол Л. М., Гайдамака О. В., Колотило О. М. 1 клас. [2018-2022]
- Музичне мистецтво. Масол Л. М., Гайдамака О. В., Колотило О. М. 1 клас. [2018-2022]
- Образотворче мистецтво. Рубля Т. Є, Щеглова Т. Л., Мед І. Л. 1 клас. [2018-2022]
- Музичне мистецтво. Рубля Т. Є, Щеглова Т. Л., Мед І. Л. 1 клас. [2018-2022]
- Образотворче мистецтво. Калініченко О. В., Аристова Л. С. 1 клас. [2018-2022]
- Музичне мистецтво. Калініченко О. В., Аристова Л. С. 1 клас. [2018-2022]
-
Навчання грамоти
-
Початкова школа. 2 клас
-
Українська мова та читання
- Українська мова та читання. Посібник. К. Пономарьова, О. Савченко. І. Красуцька. 2 клас. 2024 року випуску
- Українська мова та читання. Посібник. М. Вашуленко, О. Вашуленко, С. Дубовик. 2 клас. 2024 року випуску
- Українська мова та читання. Вашуленко М. С., Дубовик С. Г. (Частина 1); Вашуленко О. В. (Частина 2). 2 клас. [2019-2023]
- Українська мова та читання. Пономарьова К. І. (Частина 1); Савченко О. Я. (Частина 2). 2 клас. [2019-2023]
- Українська мова та читання. Большакова І. О.; Пристінська М. С. 2 клас. [2019-2023]
- Українська мова та читання. Захарійчук, М. Д. (Частина 1); Богданець-Білоскаленко, Н. І. (Частина 2 ). 2 клас. [2019-2023]
- Українська мова та читання. Н. Кравцова, В. Романова, А. Савчук. 2 клас. [2019-2023]
-
Математика
- Математика. Підручник. Листопад Н. П. 2 клас. 2025 року випуску
- Математика. Посібник (3 частини). Листопад Н. П. 2 клас. 2024 року випуску
- Математика. Посібник. Скворцова, С. О., Онопрієнко О. В. 2 клас. 2024 року випуску
- Математика. Посібник. Гісь О. М., Філяк І. В. 2 клас. 2024 року випуску
- Математика. Скворцова, С. О., Онопрієнко О. В. (зош. 4 частини) 2 клас. [2019-2023]
- Математика. Листопад Н. П. 2 клас. [2019-2023]
- Математика. Лишенко Г. П. 2 клас. [2019-2023]
- Математика. Гісь О. М., Філяк І. В. 2 клас. [2019-2023]
- Математика. Заїка А.М. 2 клас. [2019-2023]
- Математика. С. Логачевська, Т. Логачевська, О. Комар. 2 клас. [2019-2023]
-
Я досліджую світ
- Я досліджую світ. Гільберг Т. Г.; Тарнавська С. С.; Павич Н. Н. 2 клас. 2024 року випуску
- Я досліджую світ. Бібік Н. М., Бондарчук Г. П. 2 клас. 2024 року випуску
- Я досліджую світ. І. Жаркова, Л. Мечник. 2 клас. 2024 року випуску
- Я досліджую світ. Т. В. Воронцова, В. С. Пономаренко. 2 клас. До підручника 2025 року випуску
- Я досліджую світ. О. Волощенко, О. Козак. 2 клас. До підручника 2025 року випуску
- Я досліджую світ. Гільберг Т. Г.; Тарнавська С. С.; Павич Н. Н. 2 клас. [2019-2023]
- Я досліджую світ. Бібік Н. М., Бондарчук Г. П. 2 клас. [2019-2023]
- Я досліджую світ. Грущинська І. В., Хитра З. М. 2 клас. [2019-2023]
- Я досліджую світ. Волощенко О. В., Козак О. П., Остапенко Г. С. 2 клас. [2019-2023]
- Я досліджую світ. Т. В. Воронцова, В. С. Пономаренко, О. Л. Хомич, І. В. Гарбузюк, Н. В. Андрук, К. С. Василенко. 2 клас. [2019-2023]
- Я досліджую світ. Большакова І.О., Пристінська М.С. 2 клас. [2019-2023]
- Я досліджую світ. Н. Будна, Т. Гладюк, С. Заброцька, Л. Лисобей, Н. Шост. 2 клас. [2019-2023]
-
Дизайн і технології
- Дизайн і технології. Гільберг Т. Г.; Тарнавська С. С.; Павич Н. Н. 2 клас. До підручника 2024 року випуску
- Дизайн і технології. Корнієнко М.М., Крамаровська С.М., Зарецька І.Т. 2 клас. До підручника 2024 року випуску
- Дизайн і технології. Гільберг Т. Г.; Тарнавська С. С.; Павич Н. Н. 2 клас. [2019-2023]
- Дизайн і технології. Корнієнко М.М., Крамаровська С.М., Зарецька І.Т. 2 клас. [2019-2023]
- Дизайн і технології. Морзе Н. В., Барна О. В. 2 клас. [2019-2023]
- Дизайн і технології. Волощенко О. В., Козак О. П., Остапенко Г. С. 2 клас. [2019-2023]
- Дизайн та технології. Т. В. Воронцова, В. С. Пономаренко, О. Л. Хомич, І. В. Гарбузюк, Н. В. Андрук, К. С. Василенко. 2 клас. [2019-2023]
-
Мистецтво
- Образотворче мистецтво. Масол, Л. М., Гайдамака, О. В., Колотило О. М. 2 клас. 2024 року випуску
- Музичне мистецтво. Масол, Л. М., Гайдамака, О. В., Колотило О. М. 2 клас. 2024 року випуску
- Образотворче мистецтво. Калініченко О. В. 2 клас. До підручника 2024 року випуску
- Музичне мистецтво. Калініченко О. В. 2 клас. До підручника 2024 року випуску
- Образотворче мистецтво. Масол, Л. М., Гайдамака, О. В., Колотило О. М. 2 клас. [2019-2023]
- Музичне мистецтво. Масол, Л. М., Гайдамака, О. В., Колотило О. М. 2 клас. [2019-2023]
- Образотворче мистецтво. Рубля Т. Є., Мед І. Л., Щеглова Т. Л. 2 клас. [2019-2023]
- Музичне мистецтво. Рубля Т. Є., Мед І. Л., Щеглова Т. Л. 2 клас. [2019-2023]
- Образотворче мистецтво. Калініченко О. В., Аристова Л. С. 2 клас. [2019-2023]
- Музичне мистецтво. Калініченко О. В., Аристова Л. С. 2 клас. [2019-2023]
-
Українська мова та читання
-
Початкова школа. 3 клас
-
Українська мова та читання
- Українська мова та читання. Пономарьова К., Гайова Л.. 3 клас. До підручника 2025 року випуску
- Українська мова та читання. Вашуленко М. Вашуленко О. 3 клас. До підручника 2025 року випуску
- Українська мова та читання. Вашуленко М. С., Васильківська Н. А., Дубовик С. Г.; Вашуленко О. В. 3 клас [2020-2024]
- Українська мова та читання. Пономарьова К. І., Гайова Л. А.; Савченко О. Я. 3 клас. [2020-2024]
- Українська мова. Большакова І. О., Пристінська М. С. 3 клас [2020-2024]
- Українська мова та читання. Захарійчук М. Д.; Богданець-Білоскаленко Н. І., Шумейко Ю. М. 3 клас [2020-2024]
- Українська мова та читання. Н. Кравцова, О. Придаток, В. Романова та читання А. Савчук. 3 клас. [2020-2024]
-
Математика
- Математика. Листопад Н.П. 3 клас. До підручника 2025 року випуску.
- Математика. Скворцова С.О., Онопрієнко О.В. 3 клас. До підручника 2025 року випуску
- Математика. Скворцова С.О., Онопрієнко О.В. (зош. 4 частини). 3 клас [2020-2024]
- Математика. Листопад Н.П. 3 клас. [2020-2024]
- Математика. Лишенко Г.П. 3 клас [2020-2024]
- Математика. Гісь О.М., Філяк І.В. 3 клас [2020-2024]
- Математика. Заїка А.М., Тарнавська С.С. 3 клас [2020-2024]
- Математика. С. Логачевська, Т. Логачевська, О. Комар. 3 клас. [2020-2024]
-
Я досліджую світ
- Я досліджую світ. Гільберг Т.Г., Тарнавська С.С., Павич Н.М. 3 клас. До підручника 2025 року випуску
- Я досліджую світ. Бібік Н.М., Бондарчук Г.П. 3 клас. До підручника 2025 року випуску
- Я досліджую світ. І. Жаркова, Л. Мечник. 3 клас. 2025 року випуску
- Я досліджую світ. Гільберг Т.Г., Тарнавська С.С., Грубіян Л.В., Павич Н.М. 3 клас [2020-2024]
- Я досліджую світ. Бібік Н.М., Бондарчук Г.П. 3 клас [2020-2024]
- Я досліджую світ. Грущинська І.В., Хитра З.М. 3 клас [2020-2024]
- Я досліджую світ. Волощенко О.В., Козак О.П., Остапенко Г.С. 3 клас [2020-2024]
- Я досліджую світ. Н. Будна, Т. Гладюк, С. Заброцька, Л. Лисобей, Н. Шост. 3 клас. [2020-2024]
- Я досліджую світ. Андрусенко І.В. 3 клас [2020-2024]
- Я досліджую світ. Т. В. Воронцова, В. С. Пономаренко, О. Л. Хомич, І. В. Гарбузюк, Н. В. Андрук, К. С. Василенко. 3 клас. [2020-2024]
-
Дизайн і технології
- Дизайн і технології. Гільберг Т.Г., Тарнавська С.С., Павич Н.М. 3 клас. До підручника 2025 року випуску
- Дизайн і технології. Корнієнко М.М., Крамаровська С.М., Зарецька І.Т. 3 клас. До підручника 2025 року випуску
- Дизайн і технології. Гільберг Т.Г., Тарнавська С.С., Грубіян Л.В., Павич Н.М. 3 клас [2020-2024]
- Дизайн і технології. Корнієнко М.М., Крамаровська С.М., Зарецька І.Т. 3 клас [2020-2024]
- Дизайн і технології. Морзе Н.В., Барна О.В. 3 клас [2020-2024]
- Дизайн і технології. Волощенко О.В., Козак О.П., Остапенко Г.С. 3 клас [2020-2024]
- Дизайн і технології. Вдовенко В.В., Котелянець Н.В., Агєєва О.В. 3 клас [2020-2024]
- Дизайн та технології. Т. В. Воронцова, В. С. Пономаренко, О. Л. Хомич, І. В. Гарбузюк, Н. В. Андрук, К. С. Василенко. 3 клас. [2020-2024]
-
Мистецтво
- Образотворче мистецтво. Масол Л.М., Гайдамака О.В. 3 клас. До підручника 2025 року випуску
- Музичне мистецтво. Масол Л.М., Гайдамака О.В. 3 клас. До підручника 2025 року випуску
- Образотворче мистецтво. Калініченко О.В. 3 клас. До підручника 2025 року випуску
- Музичне мистецтво. Калініченко О.В. 3 клас. До підручника 2025 року випуску
- Образотворче мистецтво. Масол Л.М., Гайдамака О.В., Колотило О.М. 3 клас. [2020-2024]
- Музичне мистецтво. Масол Л.М., Гайдамака О.В., Колотило О.М. 3 клас [2020-2024]
- Образотворче мистецтво. Рубля Т.Є., Мед І.Л., Щеглова Т.Л. 3 клас [2020-2024]
- Музичне мистецтво. Рубля Т.Є., Мед І.Л., Щеглова Т.Л. 3 клас [2020-2024]
- Образотворче мистецтво. Калініченко О.В., Аристова Л.С. 3 клас [2020-2024]
- Музичне мистецтво. Калініченко О.В., Аристова Л.С. 3 клас. [2020-2024]
-
Українська мова та читання
-
Початкова школа. 4 клас
-
Українська мова та читання
- Українська мова та читання. Вашуленко М. С., Васильківська Н. А., Дубовик С. Г.; Вашуленко О. В. 4 клас. 2021 року випуску
- Українська мова та читання. Пономарьова К. І., Гайова Л. А. 4 клас. 2021 року випуску
- Українська мова. Большакова І., Хворостяний І. 4 клас. 2021 року випуску
- Українська мова та читання. Захарійчук М. Д.; Богданець-Білоскаленко Н. І., Шумейко Ю. М. 4 клас. 2021 року випуску
- Українська мова та читання. Н. Кравцова, В. Романова та читання А. Савчук. 4 клас. 2021 року випуску
-
Математика
- Математика. Скворцова С.О., Онопрієнко О.В. (зош. 4 частини). 4 клас. 2021 року випуску
- Математика. Листопад Н.П. 4 клас. 2021 року випуску
- Математика. Гісь О.М., Філяк І.В. 4 клас. 2021 року випуску
- Математика. Лишенко Г.П. 4 клас. 2021 року випуску
- Математика. Заїка А.М., Тарнавська С.С. 4 клас. 2021 року випуску
- Математика. С. Логачевська, Т. Логачевська. 4 клас. 2021 року випуску
-
Я досліджую світ
- Я досліджую світ. Гільберг Т.Г., Тарнавська С.С., Павич Н.М. 4 клас. 2021 року випуску
- Я досліджую світ. Бібік Н.М., Бондарчук Г.П. 4 клас. 2021 року випуску
- Я досліджую світ. Грущинська І.В., Хитра З.М. 4 клас. 2021 року випуску
- Я досліджую світ. Волощенко О.В., Козак О.П., Остапенко Г.С. 4 клас. 2021 року випуску
- Я досліджую світ. Т. В. Воронцова, В. С. Пономаренко, О. Л. Хомич, І. В. Гарбузюк, Н. В. Андрук, К. С. Василенко. 4 клас.. 2021 року випуску
- Я досліджую світ. Н. Будна, Т. Гладюк, С. Заброцька, Н. Шост. 4 клас. 2021 року випуску
- Я досліджую світ. І. Жаркова, Л. Мечник, Л. Роговська. 4 клас. До підручника 2021 року випуску
-
Дизайн і технології
- Дизайн і технології. Гільберг Т.Г., Тарнавська С.С., Павич Н.М. 4 клас. 2021 року випуску
- Дизайн і технології. Бібік Н.М., Бондарчук Г.П. 4 клас. 2021 року випуску
- Дизайн і технології. Грущинська І.В., Хитра З.М. 4 клас. 2021 року випуску
- Дизайн і технології. Волощенко О.В., Козак О.П., Остапенко Г.С. 4 клас. 2021 року випуску
- Дизайн та технології. Т. В. Воронцова, В. С. Пономаренко, О. Л. Хомич, І. В. Гарбузюк, Н. В. Андрук. 4 клас. 2021 року випуску
-
Мистецтво
- Образотворче мистецтво. Масол Л.М., Гайдамака О.В., Колотило О.М. 4 клас. 2021 року випуску
- Музичне мистецтво. Масол Л.М., Гайдамака О.В., Колотило О.М. 4 клас. 2021 року випуску
- Образотворче мистецтво. Рубля Т.Є., Мед І.Л., Щеглова Т.Л. 4 клас. 2021 року випуску
- Музичне мистецтво. Рубля Т.Є., Мед І.Л., Щеглова Т.Л. 4 клас. 2021 року випуску
- Образотворче мистецтво. Калініченко О.В., Аристова Л.С. 4 клас. 2021 року випуску
- Музичне мистецтво. Калініченко О.В., Аристова Л.С. 4 клас. 2021 року випуску
-
Українська мова та читання
-
Інформатика
- 2 Клас
- 3 Клас
-
4 Клас
- Т. Воронцова, В. Пономаренко, Л. Пономаренко, О. Хомич, І. Лаврентьєва. 4 клас.
- М.М. Корнієнко, С.М. Крамаровська, І.Т. Зарецька. Інформатика. 4 клас.
- Н. В. Морзе, О. В. Барна. Інформатика. 4 клас.
- Ломаковська Г. В., Проценко Г. О. Інформатика. 4 клас.
- Андрусич О. О. , Стеценко І. Б. Інформатика. 4 клас.
- 5 Клас
- 6 Клас
- 7 Клас
- 8 Клас
- 9 Клас
-
10-11 класи. Модулі
- Інформатика. Базовий модуль. Й.Ривкінд, Т. Лисенко, Л. Чернікова, В. Шакотько. 10-11 класи
- Інформатика. Базовий модуль. Н. Морзе. О. Барна. 10-11 класи
- Інформатика. Профільний рівень. Руденко В. Д. 10 клас
- Модуль "Вебтехнології". Інформатика. 10-11 клас.
- Модуль "Інформаційна безпека". Інформатика. 10-11 клас.
- Модуль "Документообіг". Інформатика. 10-11 клас.
- Модуль "Графічний дизайн". Інформатика. 10-11 клас.
- Модуль "Бази даних". Інформатика. 10-11 клас.
- Модуль "Комп’ютерна анімація". Інформатика. 10-11 клас.
- Модуль "3D моделювання". Інформатика. 10-11 клас.
- Модуль "Креативне програмування". Інформатика. 10-11 клас.
- Хімія
-
Українська мова та література
-
5 Клас
- Українська мова. О. Авраменко. 5 клас
- Українська мова. О. Заболотний, В. Заболотний. 5 клас
- Українська мова. Н. Голуб, О. Горошкіна. 5 клас
- Українська література. О. Авраменко. 5 клас
- Українська література. О. Калинич, С. Дячок. 5 клас
- Українська література. В. Архипова, С. Січкар, С. Шило. 5 клас
- Українська література. В.Заболотний, О. Заболотний, О. Слоньовська, І. Ярмульська. 5 клас
- Українська література. Т. Яценко, В. Пахаренко, О. Слижук. 5 клас
-
6 Клас
- Українська мова. О. Заболотний, В. Заболотний. 6 клас
- Українська мова. О. Авраменко, З. Тищенко. 6 клас
- Українська мова. Н. Голуб, О. Горошкіна. 6 клас
- Українська література. О. Калинич, С. Дячок. 6 клас
- Українська література. О. Авраменко. 6 клас
- Українська література. В. Архипова, С. Січкар, С. Шило. 6 клас
- Українська література. В.Заболотний, О. Заболотний, О. Слоньовська, І. Ярмульська. 6 клас
- Українська література. Т. Яценко, В. Пахаренко, О. Слижук. 6 клас
-
7 Клас
- Українська мова. О. Авраменко, З. Тищенко. 7 клас
- Українська література. О. Авраменко. 7 клас
- Українська мова. О. Заболотний, В. Заболотний. 7 клас
- Українська література. В.Заболотний, О. Заболотний, О. Слоньовська, І. Ярмульська. 7 клас
- Українська література. О. Калинич, С. Дячок. 7 клас. До підручника 2024 року
- Українська література. Т. Яценко. 7 клас. До підручника 2024 року
-
8 Клас
- Українська мова. О. Авраменко, З. Тищенко. 8 клас. До підручника 2025 року випуску
- Українська література. О. Авраменко. 8 клас. До підручника 2025 року випуску
- Українська мова. О. Заболотний, В. Заболотний. 8 клас. До підручника 2025 року випуску
- Українська література. В.Заболотний, О. Заболотний. 8 клас. До підручника 2025 року випуску
-
5 Клас
-
Англійська мова
-
1 Клас
- Англійська мова. О. Д. Карпюк 1 клас. До підручника 2023 року випуску
- Англійська мова. Х. К. Мітчелл 1 клас.
- Англійська мова. Герберт Пухта, Пітер Льюіс-Джонс, Світлана Дроботенко. 1 клас
- Англійська мова. Карпюк О. Д. 1 клас. [2018-2022]
- Англійська мова. Мітчелл Х. К. 1 клас. [2018-2022]
- Англійська мова. Герберт Пухта, Ґюнтер Ґернґрос, Пітер Льюіс-Джонс. 1 клас [2018-2022]
- 2 Клас
-
3 Клас
- Англійська мова. Карпюк О. Д. 3 клас. До підручника 2025 року випуску
- Англійська мова. Г.К. Мітчелл, Марілені Малкогіанні. 3 клас. До підручника 2025 року випуску
- Англійська мова. Герберт Пухта, Ґюнтер Ґернґрос. 3 клас. До підручника 2025 року випуску
- Англійська мова. С. Губарєва, О. Павліченко. 3 клас. До підручника 2025 року випуску
- Англійська мова. Карпюк О. Д. 3 клас. [2020-2024]
- Англійська мова. Г.К. Мітчелл, Марілені Малкогіанні. 3 клас. [2020-2024]
- Англійська мова. Герберт Пухта, Ґюнтер Ґернґрос, Пітер Льюіс-Джонс. 3 клас [2020-2024]
- Англійська мова. С. Губарєва, О. Павліченко. 3 клас. [2020-2024]
- 4 Клас
- 5 Клас
- 6 Клас
- 7 Клас
- 8 Клас
-
9 Клас
- 10 Клас
- 11 Клас
-
1 Клас
-
Зарубіжна література
-
Математика. Алгебра та геометрія
-
Пізнаємо природу. Довкілля. Природничі науки
-
Здоров’я, безпека та добробут
-
5 Клас
- Здоров’я, безпека та добробут. Воронцова Т. В., Пономаренко В. С., Лаврентьєва І. В., Хомич О. Л. 5 клас
- Здоров’я, безпека та добробут. О. Шиян, О. Волощенко, В. Дяків, О. Козак, А. Седоченко. 5 клас
- Здоров’я, безпека та добробут. Н. Гущина, І. Василашко. 5 клас
- Здоров’я, безпека та добробут. О. Талгіна. 5 клас
-
6 Клас
- Здоров’я, безпека та добробут. О. Шиян, О. Волощенко, В. Дяків, О. Козак, А. Седоченко. 6 клас
- Здоров’я, безпека та добробут. Воронцова Т. В., Пономаренко В. С., Лаврентьєва І. В., Хомич О. Л. 6 клас
- Здоров’я, безпека та добробут. Н. Гущина, І. Василашко. 6 клас
- Здоров’я, безпека та добробут. О. Талгіна. 6 клас
- 7 Клас
- 8 Клас
-
5 Клас
-
Етика. Вчимося жити разом. Культура добросусідства
-
5 Клас
- Культура добросусідства. М.Араджионі , І.Унгурян. 5 клас
- Етика. О. Данилевська. 5 клас
- Етика. Л. Давидюк, А. Мельник. 5 клас
- Етика. Мелещенко Т. В., Желіба О. В., Бакка Т. В., Ашортіа Є. Д., Козіна Л. Є. 5 клас
- Етика. О. Мартинюк, О. Гісем. 5 клас
- Вчимося жити разом. Воронцова Т.В., Пономаренко В. С., Василенко К. С., Лаврентьєва І. В.,. Андрук Н. В. 5 клас
- 6 Клас
-
5 Клас
-
Історія. Досліджуємо історію і суспільство. Громадянська освіта
-
5 Клас
- Вступ до історії України. І. Щупак, О. Бурлака, І. Піскарьова, А. Посунько. 5 клас.
- Вступ до історії України. О. Гісем. О. Мартинюк. 5 клас.
- Вступ до історії України. В. Власов, І. Гирич, О. Данилевська. 5 клас.
- Досліджуємо історію і суспільство. Васильків І. Д., Басюк О. Я., Гінкул Г. С., Грисюк Л. А. 5 клас
- Досліджуємо історію і суспільство. Пометун О.І., Ремех Т.О., Малієнко Ю.Б., Мороз П.В. 5 клас
- 6 Клас
-
7 Клас
- Всесвітня історія. І.Я. Щупак, О.В. Бурлака, О.В. Желіба, І.О. Піскарьова. 7 клас
- Історія України. І.Я. Щупак, О.В. Бурлака, В. Дрібниця, О.В. Желіба, І.О. Піскарьова. 7 клас
- Всесвітня історія. О. Пометун, Ю. Малієнко, О. Дудар. 7 клас
- Історія України. О. Пометун, О. Дудар, Н. Гупан. 7 клас
- Всесвітня історія. О. Гісем, О. Мартинюк. 7 клас
- Історія України. А. Галімов, О. Гісем, О. Мартинюк. 7 клас
-
8 Клас
- Весвітня історія. Щупак І. Я., Старченко Н. П. 8 клас. До підручника 2025 року випуску
- Історія України. Щупак І. Я., Секиринський Д. О. 8 клас. До підручника 2025 року випуску
- Всесвітня історія. О. Гісем, О. Мартинюк. 8 клас. До підручника 2025 року випуску
- Історія України. А. Галімов, О. Гісем, О. Мартинюк. 8 клас. До підручника 2025 року випуску
- Громадянська освіта. Васильків І. Д., Кравчук В. М. 8 клас. До підручника 2025 року випуску
- Громадянська освіта. О. Пометун, Т. Ремех. 8 клас. До підручника 2025 року випуску
-
5 Клас
-
Мистецтво
-
5 Клас
- Образотворче мистецтво. Масол Л. М., Просіна О. В. 5 клас.
- Музичне мистецтво. Масол Л. М., Просіна О. В. 5 клас
- Образотворче мистецтво. Л. Кондратова, С. Федун, О. Чорний. 5 клас.
- Музичне мистецтво. Л. Кондратова, С. Федун, О. Чорний. 5 клас
- Музичне мистецтво. О. Гайдамака, Н. Лємєшева. 5 клас
- Образотворче мистецтво. О. Гайдамака, Н. Лємєшева. 5 клас
- 6 Клас
-
7 Клас
- Образотворче мистецтво. Л. Масол, О. Калініченко. 7 клас.
- Музичне мистецтво. Л. Масол, О. Калініченко. 7 клас.
- Образотворче мистецтво. Л. Кондратова. 7 клас.
- Музичне мистецтво. Л. Кондратова. 7 клас
- Образотворче мистецтво. О. Гайдамака, Н. Лємєшева. 7 клас. До підручника 2024 року випуску
- Музичне мистецтво. О. Гайдамака, Н. Лємєшева. 7 клас. До підручника 2024 року випуску
- 8 Клас
-
9 Клас
-
5 Клас
-
Географія
-
Біологія
-
Технології
- Підприємництво і фінансова грамотність
- Головна
- Початкова школа. 3 клас
- Я досліджую світ
- Я досліджую світ. Андрусенко І.В. 3 клас [2020-2024]
- №037 - Значення грибів.
Урок №37 для 3 класу з Я досліждую світ за І. Андрусенко - Значення грибів.

«____»___________.20___ року
Конспект уроку «Я досліджую світ» з використанням навчального посібника І.В.Андрусенко, Н. В. Котелянець, В. В. Вдовенко, О. В
Урок №37. Значення грибів.
Мета: надати уявлення про організми - тіла живої природи: гриби; вчити ознаки грибів, органи, умови, необхідні для життя різних організмів (грибів); вчити розпізнавати і називати гриби різних груп (по 2-3 представники); виявляти пізнавальну активність на уроках; робити висновок про зв’язки організмів між собою і з неживою природою, виявляти емоційно-ціннісне ставлення до представників живої природи, піклуватися про них; виховувати дружні стосунки в класі, спільноті, розвивати увагу, мислення, мовлення.
Обладнання: мультимедійний комплект
Хід уроку
ОК (організація класу)
Створення позитивного психологічного клімату класу.
МНД (мотивація навчальної діяльності)
АОЗ (актуалізація опорних знань)
ВНМ (вивчення нового матеріалу)
Демонстрація навчальної презентації.
Слайд2. Ранкове коло.
Слайд3. Програма «Як почуває себе ненька Україна?» в прямому ефірі.
Слайд4. Відгадай загадку.
Слайд5. Побесідуймо.
Слайд6. Що таке гриби?
Слайд7. Розглянь будову гриба.
Слайд8. Рухлива вправа.
Слайд9. Довідничок.
Слайд10. Запам’ятай.
Слайд11. Прослухаймо казку «Під грибом»
Слайд12. Побесідуймо.
Слайд13. Слово вчителя.
Слайд14. Є мікроскопічні гриби.
Слайд15. Є гриби гіганти.
Слайд16. До грибів належить цвіль.
Слайд17. До грибів належать дріжджі.
Слайд18. Гриби є в заквасках для кисломолочних продуктів.
Слайд19. Фізкультхвилинка.
Слайд20. Розглянь схему. Яку роль гриби відіграють у природі та житті людини?
Слайд21. Чи знаєте ви, що…
Слайд22. Вправа «Незакінчене речення»
Слайд23. Для роздумів.
Слайд24. Доповни схему.
Слайд25. Цікавинка.
Слайд26. Висновок.
Слайд27. Поміркуй.
Слайд28. Домашнє завдання
ЗВ (закріплення вивченого)
Слайд29. Як пов'язане життя гриба і дерева?
Підсумок.
Рефлексія.
В уроці присутні:
- План-конспект
- Фізкультхвилинка
- Мультимедійна презентація
або 6.66 грн/урок у комплекті
Від 6.66 грн/урок
- Миттєвий доступ після оплати
- Зручно дивитися на будь-якому пристрої
- Відповідає програмі НУШ
- Миттєвий доступ після оплати
- Зручно дивитися на будь-якому пристрої
- Відповідає програмі НУШ
ТЕХНІЧНІ МІНІМАЛЬНІ ВИМОГИ
1. Операційна система:
- Windows 10 / Windows 11 (64-bit);
- macOS 12.0 (Monterey) або новішою;
- iOS 15+ чи Android 11+ (для мобільних пристроїв).
2. Офісне програмне забезпечення. Для коректного відкриття матеріалів рекомендовано пакет програмного забезпечення Microsoft Office 2021 або новішу версію (рекомендовано Microsoft 365). Допускається використання LibreOffice версії 7.5 і вище (дане програмне забезпечення є альтернативним, і потрібно розуміти, що можливе візуальне зміщення шрифтів, зображень, а також проблеми з відтворення мультимедіа чи відображенням зображень). Використання версій Microsoft Office, старіших за 2021 рік, може призвести до некоректного відображення презентацій, шрифтів, відео та анімацій.
3. Архіватор. Для розпакування файлів необхідно вкористовувати:
- Windows 10 / Windows 11 (64-bit) мати встановлений програмний засіб для розпаковування архівів 7-Zip 19.0+. Завантаження даного архіватора доступне на офіційному сайті розробника - https://www.7-zip.org, (Альтернативний архіватор - WinRAR 6.0+).
- MacOS 12.0 (Monterey) або новішою мати встановлений програмний засіб https://apps.apple.com/us/app/unzip-zip-file-opener/id1281374098 або https://apps.apple.com/us/app/zip-rar-file-extractor/id769409043
- iOS 15+ чи Android 11+ (для мобільних пристроїв) мати встановлений програмний засіб https://play.google.com/store/apps/details?id=com.rarlab.rar&hl=uk&gl=US
4. Мультимедійна підтримка. Пристрій має підтримувати сучасні медіакодеки (H.264 / AAC), необхідні для відтворення відео й аудіо, вбудованих у презентації. Для роботи з анімаціями необхідна підтримка DirectX 12+ (Windows) або Metal (macOS). У разі відсутності програмно забезпечення QuickTime https://support.apple.com/ru-ru/106375 можлива помилка під час відтворення вбудованого відео в презентацію, а саме «Носій відсутній».
5. Мінімальні технічні характеристики обладнання:
- Процесор: не нижче Intel Core i3 або AMD Ryzen 3.
- Оперативна пам’ять: від 4 ГБ (рекомендовано 8 ГБ).
- Відеокарта: інтегрована Intel UHD / AMD Vega або дискретна.
- Вільне місце на диску: не менше 2 ГБ.
- Екран: роздільна здатність не менше 1366×768 (рекомендовано Full HD 1920×1080).
6. Інтернет-з’єднання. Для завантаження матеріалів необхідне стабільне підключення до Інтернету зі швидкістю від 5 Мбіт/с. Для доступу до інтерактивних компонентів необхідно використовувати сучасний браузер (Google Chrome, Opera, Safari або Mozilla Firefox останніх версій).


 Увійти через Google
Увійти через Google
 Увійти через Facebook
Увійти через Facebook